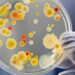
გამოვლინდა ბოტულიზმის შემთხვევა! -სურსათის ეროვნული სააგენტო მოსახლეობას აფრთხილებს

აშშ დოლარი გაუფასურდა და 2.7397 ლარი გახდა. კურსი, რომელიც დღეს მოქმედებდა 2.7401 ლარი იყო. შესაბამისად, ლარის ცვლილებამ 0.04 თეთრი შეადგინა.
გამყარდა ევრო, რომლის კურსი 3.1090 ლარი გახდა. დღეს მოქმედი კურსი 3.0815 ლარია. შესაბამისად, ეროვნული ვალუტა ევროსთან მიმართებით 2.75 თეთრით გაუფასურდა.
გამყარდა თურქული ლირა, რომლის ღირებულებაც 0.0706 ლარი გახდა.
1.67 თეთრით გაუფასურდა ლარი გირვანქა სტერლინგთან, რომლის ფასი 3.6772 ლარი გახდა.
დღევანდელი ვაჭრობის შედეგად მიღებული კურსი ძალაში 22 მაისს შევა.